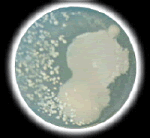
�g�p�O

|

強力な除菌・消臭能力、そして人と環境に優しい水をご存知ですか?
医療・介護・清掃事業ですでに高い評価をいただいている「プレベント」
山田歯科クリニックでは、インフルエンザ対策として、このたび「プレベント噴霧器」を導入いたしました。
エントランスおよび診療室の2カ所に設置、皆様をインフルエンザウイルスから守るために、一日中フル回転しております。
どうぞ、ご安心してご来院なさってください!
http://www.trust-prebent.com/

『プレベント』は、食品添加物として広く使われている「次亜塩素酸ナトリウム」と
「希塩酸」を、特殊技術によって水と希釈混合した、中性に近い弱酸性の除菌水です。
『プレベント』は、人間の体内で殺菌のために作られている成分に近いもので、強力な殺菌消臭力を持ち、人体と環境に優しい除菌水として、多方面で活用されています。

■寒天培地による除菌試験
使用前
除菌前の床面 |
 |
使用後

プレベント噴霧後減少 |
『プレベント』は、食品添加物同士の混合により生成されるために安全そのものです。
『プレベント』は、菌に触れたり有機物に接触すると真水に戻ります。普通の水洗いと同じ感覚でご利用いただけます。誤飲してしまった場合でも、胃腸に達する前に有機物と反応して水に戻ります。
また、水に近い状態で生成されるため、環境やお肌に非常に優しく安全です。
|

A領域:除菌力大かつ安全性大(理想の除菌領域)
B領域:除菌力大だが毒性大(従来の除菌領域)
C領域:除菌力小だが安全性大(従来の除菌領域)
D領域:除菌力小のうえに毒性大(使用されなくなる除菌領域)
|
|